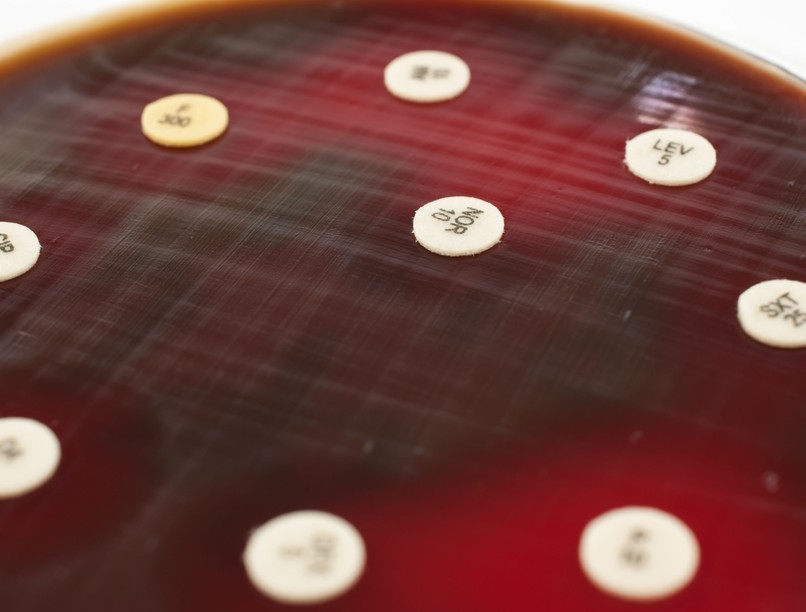
pneumococcus baktérium fertőzés

A pneumococcus baktérium okozta fertőzés akár komoly veszélyt is jelenthet
A nyári hónapokban hajlamosak lehetünk megfeledkezni a légutakat érintő megbetegedésekről, de most már beköszöntött az ősz, és ezzel együtt a légúti vírusfertőzések és bakteriális társfertőzések időszaka, így nem árt az óvatosság. A megelőzés lehetőségeiről egészségügyi szakemberrel is konzultálhatunk.
- A légúti fertőzések időszakában tartsunk távolságot a tüneteket mutató emberektől.
- Betegen ne menjünk közösségbe.
- Lehetőleg kerüljük a zsúfolt helyeket és ügyeljünk a higiéniára, mely magában foglalja például a rendszeres kézmosást, felületek fertőtlenítését.
- Ha pedig krónikus betegségünk van, érdemes rendszeres orvosi konzultációra járni.
- A megelőzésre való odafigyelés mellett azonban lehetőség szerint mozogjunk gyakran, aknázzuk ki a hűvösebb hónapok kínálta élvezeteket is.
A légutakon keresztül, cseppfertőzéssel terjedő vírusok közül az új típusú koronavírus, az influenzavírus vagy a légúti óriássejtes vírus (RSV) önmagában is veszélyes lehet és fokozott egészségügyi kockázatot jelenthet a népesség több csoportjára. E vírusok okozta légúti betegségeket gyakran kísérhetik bakteriális társfertőzések, amelyek a betegség lefolyását súlyosabbá tehetik.1,2
Az influenza esetek több mint 35%-ban alakulhatnak ki kórházi kezelést igénylő bakteriális társfertőzések, mint például a pneumococcus baktérium okozta bakteriális tüdőgyulladás.2,3
A pneumococcus baktérium számos betegség okozója lehet, főleg az idősek és a csecsemők, kisgyermekek körében. A fertőzés cseppfertőzéssel terjed. A baktériumot az óvodás korú gyermekek tünetmentesen is hordozhatják az orr-garat nyálkahártyáján.
Gyengébb immunrendszer esetén, például időseknél vagy krónikus betegeknél, illetve egy influenza vagy RSV fertőzés után a baktérium megfertőzheti a tüdőt, ezzel egyes esetekben tüdőgyulladást okozva, vagy bizonyos esetekben a véráramba kerülhet, és ott súlyos betegségeket – agyhártyagyulladást, vérmérgezést, és ezek együttes előfordulását – is okozhat.3,4
Felnőttek esetében a pneumococcus okozta tüdőgyulladás kialakulásának gyakorisága 50 éves kortól emelkedhet az immunrendszer öregedése és a krónikus betegségek kialakulása miatt. A megfelelő antibiotikum szedése általában gyógyulást eredményez, azonban súlyosabb esetekben kórházi kezelést igényelhet. Veszélyeztetett korosztályhoz tartozónak számítanak a 65 évnél idősebbek, akiknél a pneumococcus-fertőzés súlyos tüdőgyulladást is okozhat.5
A pneumococcus által okozott fertőzések előfordulása, a szövődmények esetleges súlyossága, vagy a kórokozó antibiotikumokkal szembeni rezisztenciája miatt bizonyos életkorban és állapotokban fontos lehet a megelőzés, így például a védőoltások alkalmazása, melyek segíthetnek a megelőzésben.4,5
A pneumococcus elleni oltás javasolt: 2 éves kor alatt és 50 éves kor felett mindenkinek, krónikus betegeknek, akik alapbetegségük miatt fogékonyabbak a súlyos pneumococcus fertőzésre: többek között tüdő (COPD, asztma) -, szív-, vese-, máj- és cukorbetegeknek, immunsérülteknek, dohányosoknak, valamint léphiányosoknak.6
Egy betegséget jobb megelőzni, mint elszenvedni: az oltások pedig nemcsak a betegségek kialakulását segíthetnek megelőzni, hanem felvételükkel a körülöttünk élőkért is, ezzel saját egészségünkön túl, szeretteink, ismerőseink jóllétéért is tehetünk. Védőoltás felvételével csökkenthetjük a fertőzés terjedésének kockázatát a családtagok, iskolatársak vagy kollégák, barátok, szomszédok és a közösség más tagjai körében is.7
Elkaphatom-e az influenzát, influenza oltás után?
Referenciák:
1. Metersky ML, Masterton RG, Lode H, File TM Jr, Babinchak T. Epidemiology, microbiology, and treatment considerations for bacterial pneumonia complicating influenza. Int J Infect Dis. Vol 16, Issue 5, May 2012, Pages e321-e331 https://doi.org/10.1016/j.ijid.2012.01.003
2. Morris DE, Cleary DW, Clarke SC. Secondary bacterial infections associated with influenza pandemics. Front Microbiol. 2017;8:1041. doi:10.3389/fmicb.2017.01041.
3. Klein EY, Monteforte B, Gupta A, et al. The frequency of influenza and bacterial coinfection: a systematic review and meta-analysis. Influenza Other Respir Viruses. 2016;10(5):394-403. doi:10.1111/irv.12398.
4. Takehiko Shibata at al. Respiratory syncytial virus infection exacerbates pneumococcal pneumonia via Gas6/Axl-mediated macrophage polarization. J Clin Invest. 2020; HYPERLINK “http://www.jci.org/130/6” 130(6):3021-3037. https://doi.org/10.1172/JCI125505.
5. Nemzeti Népegészségügyi és Gyógyszerészeti Központ Egészségvonal Pneumococcusfertőzés. https://egeszsegvonal.gov.hu/p-q/1409-pneumococcusfertozes.html Utolsó megtekintés: 2023.10.24.
6. Védőoltási Módszertani levél a 2023 évi védőoltásokról Elérhető: https://www.antsz.hu/felso_menu/temaink/jarvany/modszertani_levelek Utolsó megtekintés: 2023.10.24.
7. Európai Vakcinázási Információs Portál A védőoltás előnyei a közösség számára. Elérhető: https://vaccination-info.eu/hu/veA védőoltás előnyei a közösség számára Utolsó megtekintés: 2024.10.24.
PP-PRV-HUN-0073
Lezárás dátuma: 2023.10.26. NNGYK engedélyszám: OGYÉI/64440-2/2023 A jelen anyag a biztonságos és gazdaságos gyógyszer- és gyógyászatisegédeszköz-ellátás, valamint a gyógyszerforgalmazás általános szabályairól 2006. évi XCVIII. törvény (Gyftv.) 17. § (5) bekezdése szerinti egészségnevelési célú –az egészségügyi államigazgatási szerv által egyedileg engedélyezett védőoltási programot népszerűsítő kampány része.
Pfizer Gyógyszerkereskedelmi Kft.
1123 Budapest, Alkotás u. 53. MOM Park, “A” épület
Tel.: 06-1-488-3700, www. pfizer.hu
Prevenar 13 szuszpenziós injekció, adszorbeált pneumococcus poliszacharid konjugált vakcina (13-valens), amely a Streptococcus pneumoniae baktérium 13 típusa által okozott betegségek megelőzésére szolgál. Orvosi rendelvényhez kötött gyógyszer.
A kockázatokról és a mellékhatásokról olvassa el a betegtájékoztatót, vagykérdezze meg kezelőorvosát, gyógyszerészét!
Kövesse az Egészségkalauz cikkeit a Google Hírek-ben, a Facebook-on, az Instagramon vagy a X-en,Tiktok-on is!